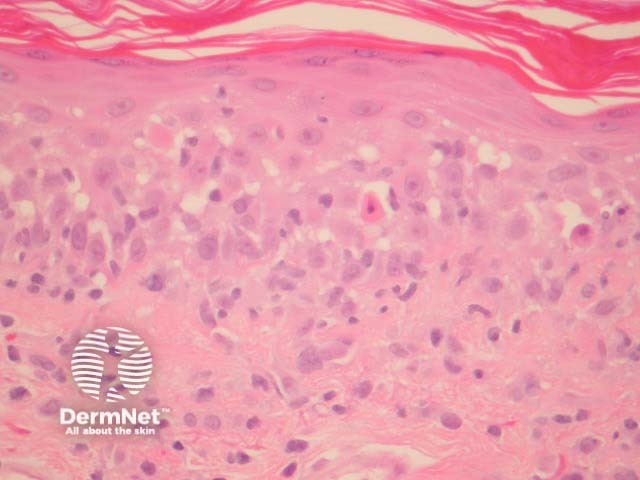
Figure 2

Main menu
Common skin conditions
NEWS
Join DermNet PRO
Read more
Quick links
Systemic diseases Autoimmune/autoinflammatory Diagnosis and testing
Author: Assoc Prof Patrick Emanuel, Dermatopathologist, Auckland, New Zealand, 2014.
Paraneoplastic pemphigus is a rare form of pemphigus associated with internal malignancies. Lymphoma is the most commonly described associated malignancy but numerous other tumour associations have been described. The clinical presentation is quite varied with some eruptions resembling erythema multiforme, pemphigoid and graft-versus-host disease.
In paraneoplastic pemphigus, there is usually an overt interface or lichenoid infiltrate associated with necrotic keratinocytes at all levels of the epidermis (figures 1-3) to resemble erythema multiforme. In addition, foci of suprabasal acantholysis are seen. Sometimes the acantholysis can be very difficult to find making diagnosis difficult.

Figure 1
Figure 2

Figure 3
Direct immunofluorescence usually shows intercellular and basement membrane deposition of IgG and C3.
The features histologically resemble lichenoid eruptions (such as erythema multiforme, lichen planus, drug eruptions), and other immunobullous diseases (pemphigus vulgaris). Correlation with the clinical findings and immunofluorescence is invaluable in arriving at the correct diagnosis.